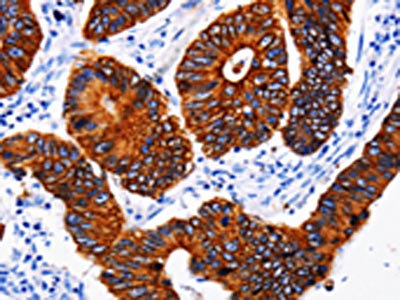

KRT6A Antibody
-
中文名稱:KRT6A兔多克隆抗體
-
貨號:CSB-PA160649
-
規(guī)格:¥1100
-
圖片:
-
其他:
產(chǎn)品詳情
-
Uniprot No.:
-
基因名:KRT6A
-
別名:CK-6A antibody; CK-6D antibody; CK6A antibody; CK6C antibody; CK6D antibody; Cytokeratin-6A antibody; Cytokeratin-6D antibody; K2C6A_HUMAN antibody; K6A antibody; K6C antibody; K6D antibody; keratin 6A antibody; Keratin antibody; Keratin; type II cytoskeletal 6A antibody; Keratin-6A antibody; Krt6a antibody; KRT6C antibody; KRT6D antibody; type II cytoskeletal 6A antibody; Type-II keratin Kb6 antibody
-
宿主:Rabbit
-
反應(yīng)種屬:Human,Mouse,Rat
-
免疫原:Fusion protein of Human KRT6A
-
免疫原種屬:Homo sapiens (Human)
-
標(biāo)記方式:Non-conjugated
-
抗體亞型:IgG
-
純化方式:Antigen affinity purification
-
濃度:It differs from different batches. Please contact us to confirm it.
-
保存緩沖液:-20°C, pH7.4 PBS, 0.05% NaN3, 40% Glycerol
-
產(chǎn)品提供形式:Liquid
-
應(yīng)用范圍:ELISA,IHC
-
推薦稀釋比:
Application Recommended Dilution ELISA 1:1000-1:5000 IHC 1:25-1:100 -
Protocols:
-
儲存條件:Upon receipt, store at -20°C or -80°C. Avoid repeated freeze.
-
貨期:Basically, we can dispatch the products out in 1-3 working days after receiving your orders. Delivery time maybe differs from different purchasing way or location, please kindly consult your local distributors for specific delivery time.
-
用途:For Research Use Only. Not for use in diagnostic or therapeutic procedures.
相關(guān)產(chǎn)品
靶點(diǎn)詳情
-
功能:Epidermis-specific type I keratin involved in wound healing. Involved in the activation of follicular keratinocytes after wounding, while it does not play a major role in keratinocyte proliferation or migration. Participates in the regulation of epithelial migration by inhibiting the activity of SRC during wound repair.
-
基因功能參考文獻(xiàn):
- Manipulating K6a phosphorylation or ubiquitin-proteasome system (UPS) activity may provide opportunities to harness the innate immunity of epithelia against infection. PMID: 29191848
- Several missense polymorphisms in KRT6A, KRT6B and KRT6C that lead to a higher risk for dental caries. PMID: 29357356
- KRT6A genetic mutation is associate with the development of Pachyonychia Congenita in patients in Australia. PMID: 27041546
- we here describe a family with pachyonychia congenita K6a, manifesting atypical symptoms of impaired wound healing and cheilitis. PMID: 24708461
- Keratin-derived antimicrobial peptides (KDAMPs) and their synthetic analogs exhibit antimicrobial activity against bacterial pathogens. PMID: 23006328
- Genotype-phenotype correlations among PC patients with codon-125 mutation in KRT16 were established, while the phenotypes caused by the IVS8-2A>C mutation in KRT6A need further studies to confirm the rare feature of fissured tongue PMID: 22668561
- We observed a higher likelihood of oral leukokeratosis in individuals harboring KRT6A mutations. PMID: 22264670
- Phenotypic differences exist between KRT6A and KRT16 mutations support adoption of a new classification system. PMID: 22098151
- This report is the first case of pachyonychia congenita with laryngeal obstruction in which the gene mutation has been established (a deletional mutation in keratin 6a). PMID: 21554383
- Focal palmoplantar keratoderma is associated with mutations in keratin K6c in 3 families. 2 unrelated families have Asn172 del and the other has a deletion of AA 462-470. Review. PMID: 20470930
- these data highlight the possibility of a physiological role for K6/K16 heterodimers in keratinocyte cell migration, in addition to the heterodimer's known functions in cell differentiation and mechanical resilience. PMID: 20403371
- The mutation of 521T--> C in the K6A gene is the causing mutation in pachyonychia congenita type I. PMID: 20140871
- Mutations Y465H and N171D of the KRT16A gene were detected in the sporadic pachyonychia congenita cases. PMID: 19806570
- Four new missense and five known mutations in K6a, one new deletion and three previously identified missense mutations in K16, plus one known mutation in K17 are reported in pachyonychia congenita. PMID: 17719747
- PC-1 is due to mutations of the KRT16 gene or its expression partner KRT6A, wheres PC-2 is caused by mutations in the KRT17 or KRT6B genes. PMID: 18489596
- Three novel and four recurrent keratin 6A (KRT6A) mutations were found in Chinese patients with pachyonychia congenita type 1 PMID: 19416275
- Rapamycin selectively inhibits expression of an inducible keratin (K6a) in human keratinocytes and improves symptoms in pachyonychia congenita patients. PMID: 19699613
顯示更多
收起更多
-
相關(guān)疾病:Pachyonychia congenita 3 (PC3)
-
蛋白家族:Intermediate filament family
-
組織特異性:Expressed in the corneal epithelium (at protein level).
-
數(shù)據(jù)庫鏈接:
Most popular with customers
-
Phospho-YAP1 (S127) Recombinant Monoclonal Antibody
Applications: ELISA, WB, IHC
Species Reactivity: Human
-
-
-
-
-
-
-
VDAC1 Recombinant Monoclonal Antibody
Applications: ELISA, WB, IHC
Species Reactivity: Human, Mouse, Rat